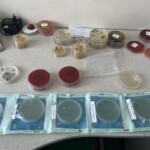
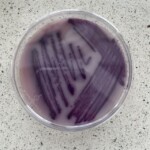

22 maja uczniowie klasy 3A razem z nauczycielkami J. Michalską i M. Brakoniecką odwiedzili laboratoria Wojewódzkiej Stacji Sanitarno-Epidemiologicznej w Poznaniu. W trakcie dwugodzinnego spotkania młodzież została wprowadzona w realia pracy laboratoryjnej związanej z bezpieczeństwem żywności, higieną środowiska oraz oceną warunków pracy. W laboratorium mikrobiologicznym uczniowie poznali metody identyfikacji i hodowli bakterii. Szczególne zainteresowanie wzbudziła prezentacja bakterii wyhodowanych z codziennie dotykanych powierzchni – m.in. z klamek i telefonów komórkowych – oraz porównanie skuteczności mycia rąk samą wodą, wodą z mydłem w porównaniu do niemycia w ogóle. Kolejnym etapem wycieczki były pracownie zajmujące się badaniem żywności pod kątem obecności organizmów modyfikowanych genetycznie (GMO) oraz oceną materiałów mających kontakt z żywnością, ze szczególnym uwzględnieniem substancji potencjalnie szkodliwych. Uczniowie odwiedzili również laboratorium badań środowiska pracy, gdzie zaprezentowano metody monitorowania czynników szkodliwych na stanowiskach pracy.
Pracownicy WSSE z ogromnym zaangażowaniem opowiadali o swojej pracy, prezentowali profesjonalny sprzęt oraz chętnie odpowiadali na pytania, dzieląc się wiedzą i doświadczeniem. Wizyta nie tylko wzbogaciła uczniów o konkretne informacje z zakresu mikrobiologii, chemii i ochrony zdrowia publicznego, ale także była doskonałą okazją do zapoznania się z możliwymi ścieżkami kariery w sektorze badań laboratoryjnych.
Serdecznie dziękujemy pracownikom WSSE w Poznaniu za życzliwe przyjęcie i poświęcony czas.
Po wyjściu z zajęć, przechodząc przez Park Moniuszki, przeprowadziliśmy krótką sesję shinrin-yoku (kąpiele leśne) – skupiając się na świadomym oddychaniu (4×4) oraz budowaniu koncentracji poprzez kontakt z naturą.